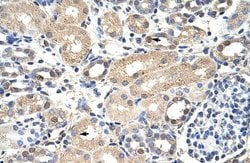
Invitrogen EXOSC7 Polyclonal Antibody 100 &mu;L; Unconjugated:Antibodies,

missing translation for 'onlineSavingsMsg'
Learn More
Learn More
Invitrogen™ EXOSC7 Polyclonal Antibody


Rabbit Polyclonal Antibody
Brand: Invitrogen™ PA541854
This item is not returnable.
View return policy
Description
Peptide sequence: LEKPNEGYLE FFVDCSASAT PEFEGRGGDD LGTEIANTLY RIFNNKSSVD Sequence homology: Cow: 100%; Dog: 100%; Guinea Pig: 100%; Horse: 100%; Human: 100%; Mouse: 100%; Rabbit: 100%; Rat: 100%; Zebrafish: 79%.
Non-catalytic component of the RNA exosome complex which has 3'->5' exoribonuclease activity and participates in a multitude of cellular RNA processing and degradation events. In the nucleus, the RNA exosome complex is involved in proper maturation of stable RNA species such as rRNA, snRNA and snoRNA, in the elimination of RNA processing by-products and non-coding 'pervasive' transcripts, such as antisense RNA species and promoter-upstream transcripts (PROMPTs), and of mRNAs with processing defects, thereby limiting or excluding their export to the cytoplasm. The RNA exosome may be involved in Ig class switch recombination (CSR) and/or Ig variable region somatic hypermutation (SHM) by targeting AICDA deamination activity to transcribed dsDNA substrates. In the cytoplasm, the RNA exosome complex is involved in general mRNA turnover and specifically degrades inherently unstable mRNAs containing AU-rich elements (AREs) within their 3' untranslated regions, and in RNA surveillance pathways, preventing translation of aberrant mRNAs. It seems to be involved in degradation of histone mRNA. The catalytic inactive RNA exosome core complex of 9 subunits (Exo-9) is proposed to play a pivotal role in the binding and presentation of RNA for ribonucleolysis, and to serve as a scaffold for the association with catalytic subunits and accessory proteins or complexes.
Specifications
| EXOSC7 | |
| Polyclonal | |
| Unconjugated | |
| EXOSC7 | |
| 2610002K22Rik; AV212732; EAP1; EGK_11725; EXOSC7; Exosome complex component RRP42; exosome complex exonuclease RRP42; exosome complex exonuclease RRP42; exosome complex component RRP42; Exosome complex exonuclease RRP42-like protein; exosome component 7; hRrp42p; hypothetical protein LOC550247; KIAA0116; mKIAA0116; p8; Ribosomal RNA-processing protein 42; RRP42; Rrp42p; zgc:110717 | |
| Rabbit | |
| Protein A | |
| RUO | |
| 23016 | |
| -20°C, Avoid Freeze/Thaw Cycles | |
| Liquid |
| Immunohistochemistry (Paraffin), Western Blot | |
| 1 mg/mL | |
| PBS with 2% sucrose and 0.09% sodium azide | |
| Q15024 | |
| EXOSC7 | |
| Synthetic peptide directed towards the N-terminal of human EXOSC7 (aa 71-120). | |
| 100 μL | |
| Primary | |
| Human | |
| Antibody | |
| IgG |
Product Content Correction
Your input is important to us. Please complete this form to provide feedback related to the content on this product.
Product Title
Spot an opportunity for improvement?Share a Content Correction